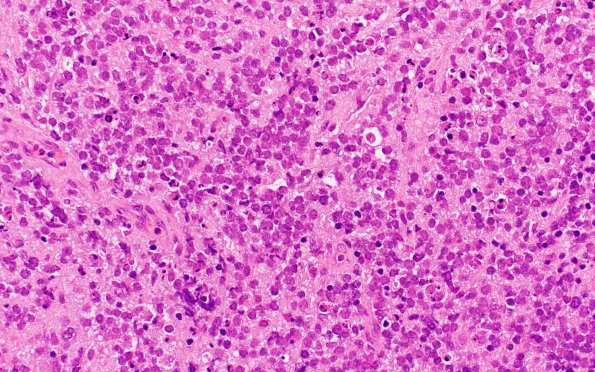
9A1 Lymphoma, DLBCL, GCT (Case 9) H&E 6

Table of Contents
Washington University Experience | NEOPLASMS (HEMATOLYMPHOID) | Lymphoma, primary | 9A1 Lymphoma, DLBCL, GCT (Case 9) H&E 6
Case 9 History ---- The patient is a 65-year-old woman with several months of worsening back and radicular pain. Abdominal, pelvic CT scan shows mixed lytic and sclerotic lesion involving the L2 vertebral body and the spinal cord extending into the central canal. Operative procedure: Spinal cord tumor resection, L1-L3 decompression and fusion. ---- 9A1,2 Hematoxylin and eosin stained sections of the spinal lesion show soft tissue and bone infiltrated by a hypercellular neoplasm. The majority of the tumor cells have hyperchromatic nuclei, speckled chromatin, occasional conspicuous nucleoli, and indistinct cell borders. In some areas, the tumor cells have large nuclei, vesicular chromatin and prominent nucleoli. There is extensive crush artifact and the stroma is vascular in many areas. Mitotic figures and karyorrhectic debris are numerous.